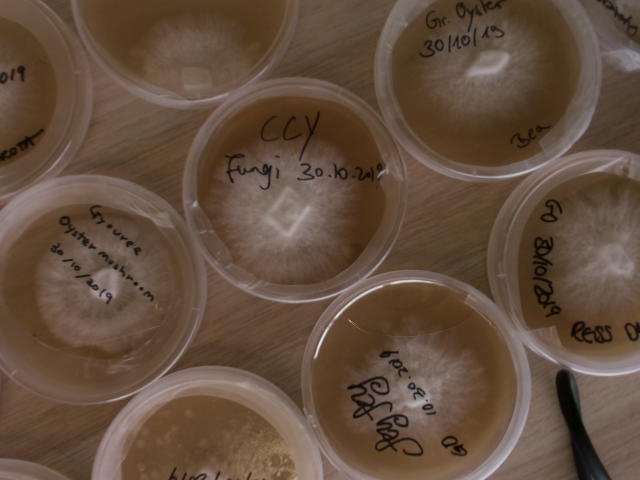

How to start to build up your mushroom culture library!
In this blog, I will go over the simple process of how one can get started with building out their fungi library of cultures. I first started growing mushrooms based off a recommendation of a friend. I was fascinated by these small organisms and never realized or knew how mushrooms even grew! I always just thought it was with some special method or soil… little did I know it was actually giant network of “nerves” that form these fruiting bodies we take for granted. I later discovered that my engineering background combined with my new found passion for mycology could help address several International Crises we’re facing in the 21st century. I spent my Covid Time building out and developing technology focused around mycelium and the benefits/synergies they can provide. This is where my innovative up-cycling technology was developed, capable of harnessing the raw nutrients from discarded food waste and giving it new life! I can speak for hours about my journey here, but this is a blog to help you get started! Weather this is a hobby, homesteading, or a passion, I think Fungi can provide amazing benefits mentally, physically, and spiritually by aligning our goals with sustainable farming practices and ethics to create a better tomorrow! One where there isn’t microplastics in food, Mycotoxins, or harmful chemicals. Now to get back onto task.
The best way to get strains and cultures are surprisingly easy. With a little bit of ingenuity and time, one can make themselves a super low budget friendly still air box to gather and clone samples. I first started with a Still Airbox and the Tyndallization method to create sterile agar agar plates, I was able to get my hands on fresh mushrooms from local grocery stores. What you want to do then is practice sterilie technique and carefully graph/clone yourself a bit of the mushroom by cutting the mushroom fruiting body in half and taking a small sliver of the living mycelium/tissue. With this tissue sample you’ll want to carefully place it onto the agar agar plate and allow the mycelium time to grow. I typically allow my agar agar plates to grow/incubate at 23 degree Celsius. Below I will highlight three processes which one can go over to achieve a sophisticated fungi library from most practical to least.
The best way to isolate fragments of a mushroom depends on the specific species of fungus and the desired outcome. Here are a few methods that are commonly used:
1. Cloning: Cloning is a common method used to isolate and grow a specific fragment of the mycelium. A small piece of the mycelium is excised from the parent fungus and transferred to a sterilized growth medium, such as agar. The fragment will then continue to grow and form a new colony.
Process of Cloning a sample of King Trumpet
2. Spore printing: Spore printing involves removing the spores from the fruiting body of a mushroom and depositing them on a sterile surface, such as filter paper or glass slides. The spores can then be collected and transferred to a growth medium for isolation and cultivation.
3. Soil or compost transfer: In some cases, it is possible to isolate fragments of the mycelium by transferring a small section of the growth medium that the fungus is growing in, such as soil or compost, to a new location. The mycelium will then continue to grow and form a new colony.
Utilizing spent mushroom substrate as a soil amendment, this will propagate the colony and potentially yield future mushrooms in your garden!
It is important to note that these methods require sterile techniques to prevent contamination by other microorganisms, as well as a controlled environment to ensure optimal growth of the fungus. Proper technique, equipment, and materials are critical to successful isolation and cultivation of fragments of a mushroom.
The last method would be self-promotion and letting us do all the hard mycology work while you get to sit back and enjoy the fruits or fruiting bodies.
4. Purchase Grain Spawn, Agar Agar Plates, or Liquid Culture from Us!